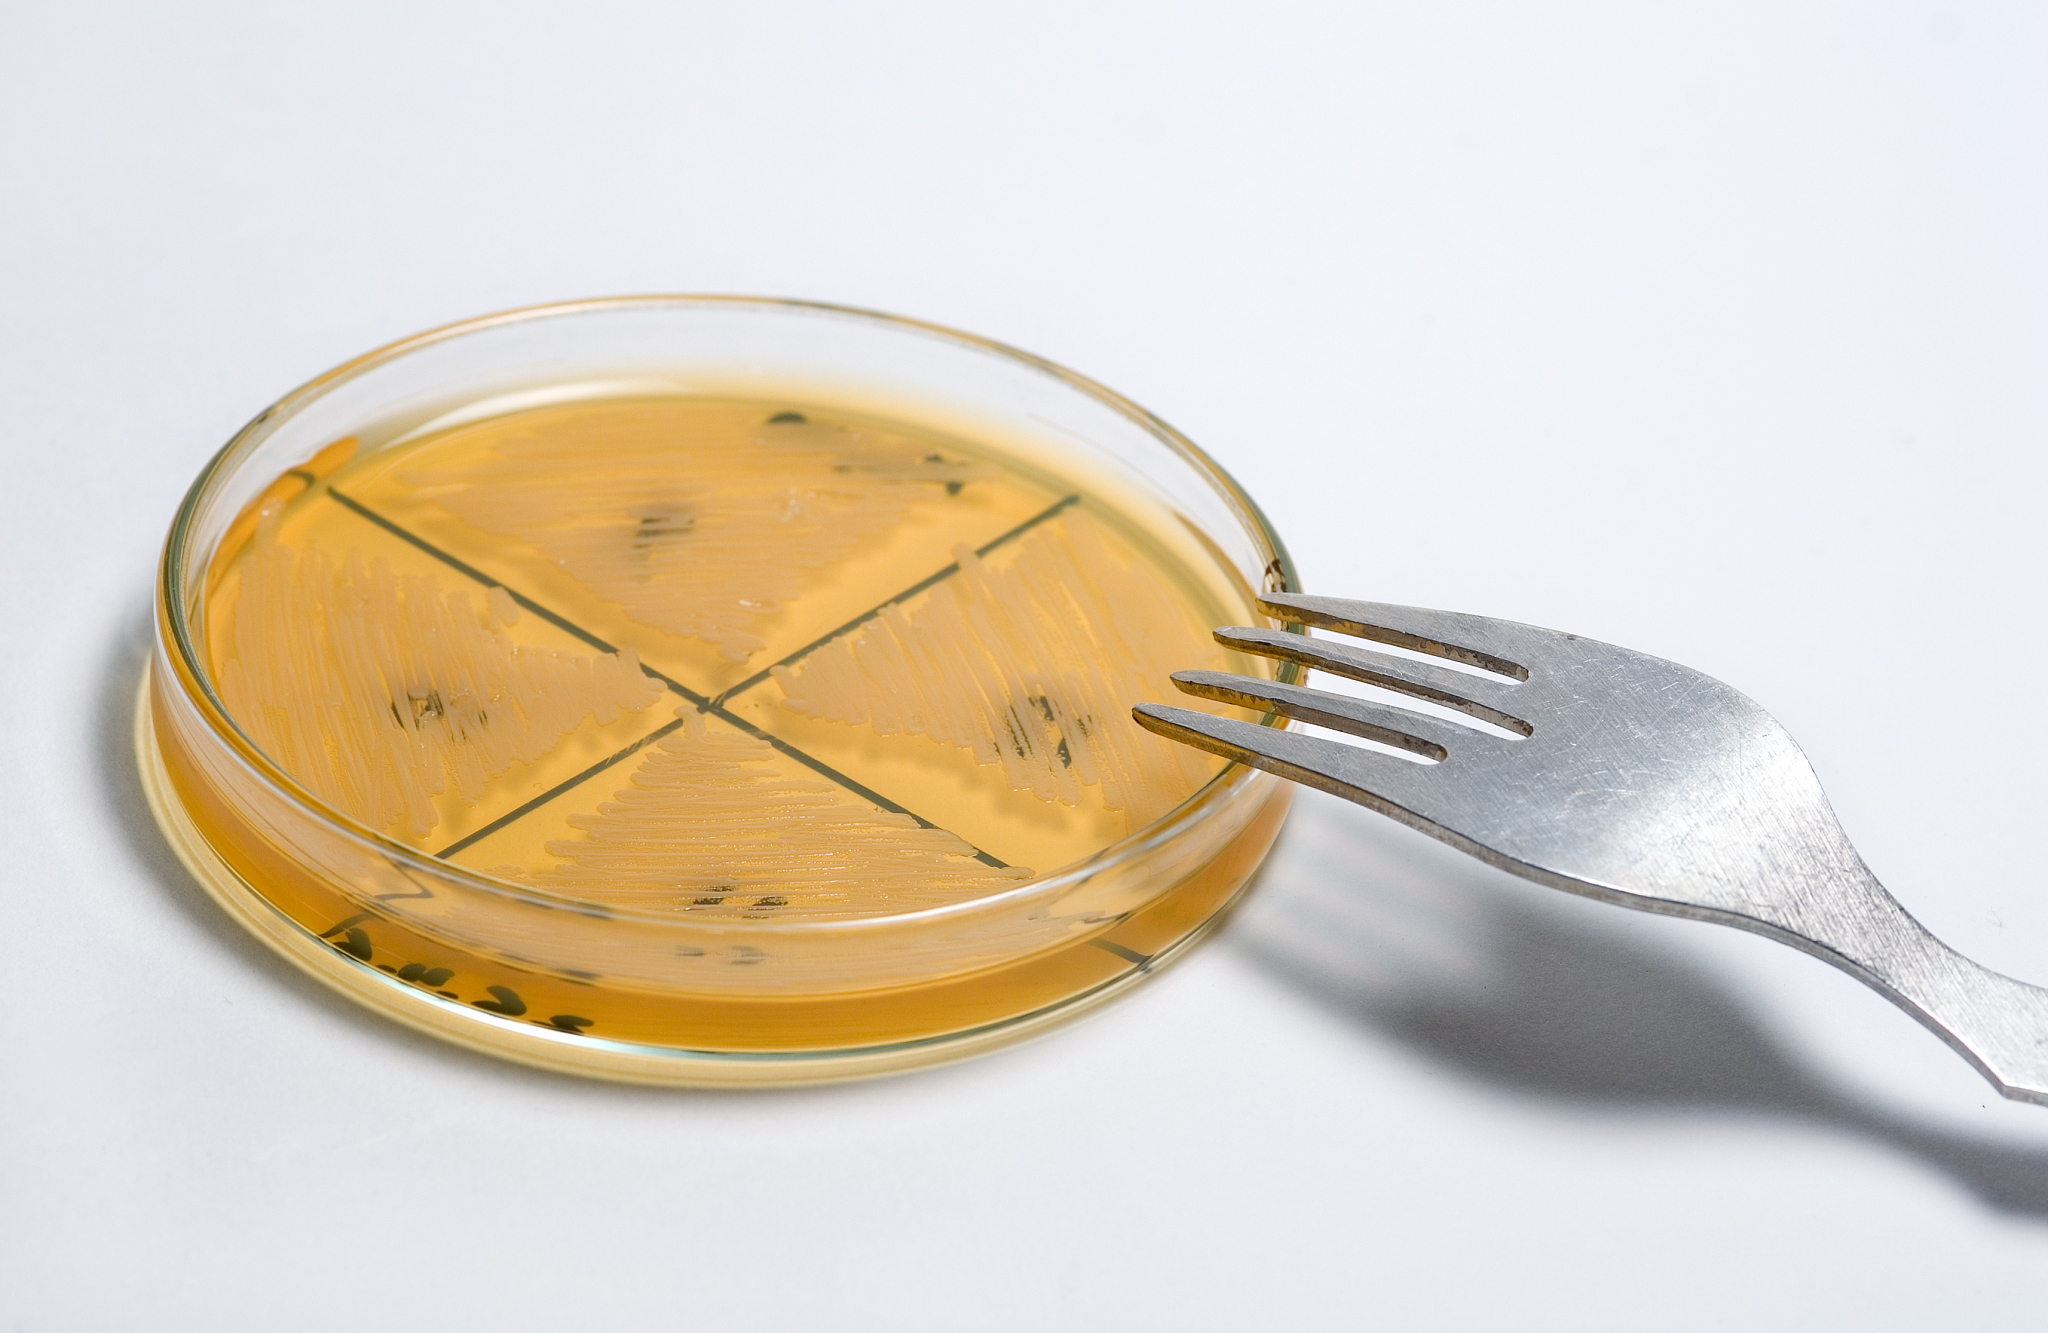
哈尔滨工业大学的食品科学与工程专业就业前景怎么样

哈尔滨工业大学的食品科学与工程专业就业前景怎么样
哈尔滨工业大学食品科学与工程专业毕业生的就业前景如何?
哈尔滨工业大学食品科学与工程专业是一门涉及食品加工、食品质量安全、食品营养与健康等方面的综合性学科,该专业的毕业生在食品加工、食品安全监管、食品营养与健康等领域都有着广泛的就业前景。
首先,哈尔滨工业大学食品科学与工程专业毕业生可以选择到食品加工企业从事研发、生产、品质控制等工作。随着人们对食品质量和安全的要求越来越高,食品加工企业对高素质、专业化的人才需求也越来越大,因此该专业毕业生在食品加工企业中有很大的就业空间。
其次,食品安全监管机构也是哈尔滨工业大学食品科学与工程专业毕业生的就业热门领域之一。随着食品安全问题的频繁发生,对食品安全监管的要求越来越高,对于有着扎实的食品科学和工程知识的毕业生,食品安全监管机构也会给予更多的就业机会。
此外,哈尔滨工业大学食品科学与工程专业毕业生还可以从事食品营养与健康领域的工作。随着人们对健康饮食的需求越来越高,对于食品营养与健康方面的专业人才也越来越多。该专业毕业生可以从事食品营养师、食品健康顾问等职业,为人们提供健康饮食方案。
综上所述,哈尔滨工业大学食品科学与工程专业毕业生的就业前景非常广阔,可以选择从事食品加工、食品安全监管、食品营养与健康等多个领域。该专业的毕业生具有扎实的专业知识和技能,具备较强的实践能力和创新能力,是社会所需的高素质、专业化、综合性人才。
####################
哈尔滨工业大学食品科学与工程专业
哈尔滨工业大学食品科学与工程专业是一门涉及食品加工、食品质量安全、食品营养与健康等方面的综合性学科。在这个专业中,学生不仅学习到了食品加工的流程和技术,还学习到了食品安全的相关知识和技能,以及食品营养与健康的理论和实践。因此,该专业的毕业生具有扎实的专业知识和技能,具备较强的实践能力和创新能力,是社会所需的高素质、专业化、综合性人才。
作为一门综合性学科,哈尔滨工业大学食品科学与工程专业的毕业生在就业市场上有着广泛的就业前景。首先,食品加工企业是该专业毕业生的主要就业领域之一。随着人们对食品质量和安全的要求越来越高,食品加工企业对高素质、专业化的人才需求也越来越大。因此,该专业毕业生在食品加工企业中有很大的就业空间。他们可以选择从事研发、生产、品质控制等工作,为企业的发展贡献自己的力量。
其次,食品安全监管机构也是哈尔滨工业大学食品科学与工程专业毕业生的就业热门领域之一。随着食品安全问题的频繁发生,对食品安全监管的要求越来越高,对于有着扎实的食品科学和工程知识的毕业生,食品安全监管机构也会给予更多的就业机会。他们可以选择从事食品安全监管、食品检验等工作,为保障人民的饮食安全做出自己的贡献。
此外,哈尔滨工业大学食品科学与工程专业毕业生还可以从事食品营养与健康领域的工作。随着人们对健康饮食的需求越来越高,对于食品营养与健康方面的专业人才也越来越多。该专业毕业生可以从事食品营养师、食品健康顾问等职业,为人们提供健康饮食方案。他们可以通过自己的专业知识和技能,帮助人们改善饮食习惯,提高身体健康水平。
综上所述,哈尔滨工业大学食品科学与工程专业毕业生的就业前景非常广泛,可以选择从事食品加工、食品安全监管、食品营养与健康等多个领域。该专业的毕业生具有扎实的专业知识和技能,具备较强的实践能力和创新能力,是社会所需的高素质、专业化、综合性人才。他们将在未来的职业生涯中为社会做出更多的贡献,成为行业的佼佼者
原文地址: https://www.cveoy.top/t/topic/e3en 著作权归作者所有。请勿转载和采集!